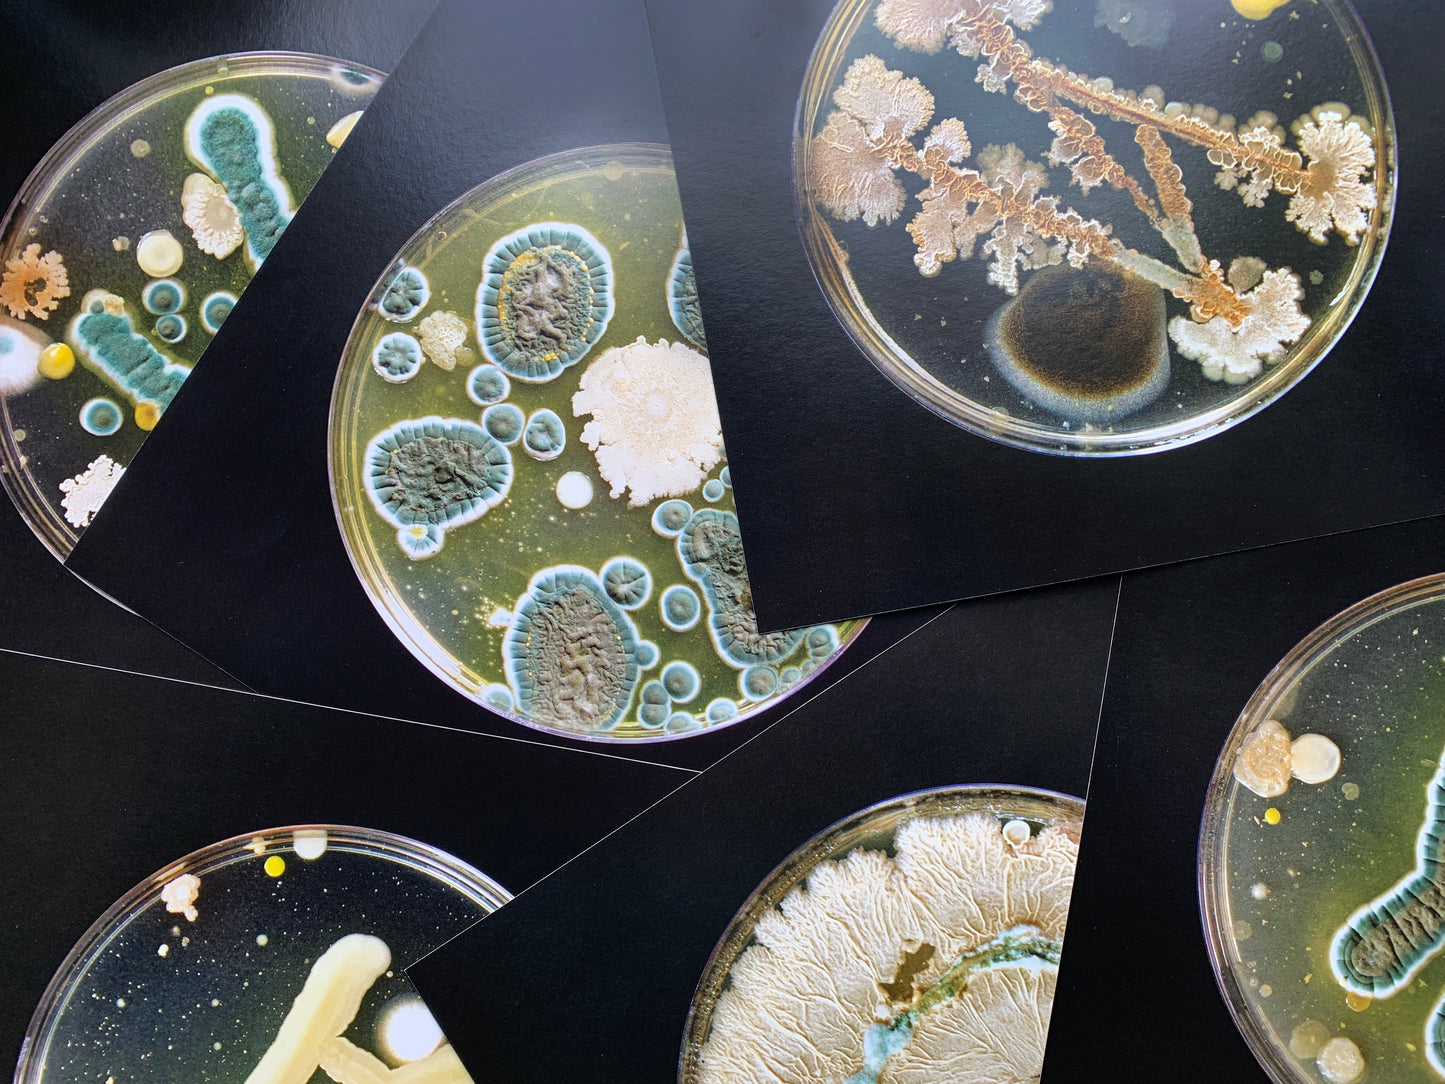

Deluxe 180gLP Art Edition pressed at Optimal (DE) in 350gsm wide spine jacket + 300gsm inner + set of six 12”x12” 300gsm art cards all printed LE-UV on uncoated Arktika artboards + DL card.
CD in custom paperboard mini-gatefold jacket + inner disc sleeve.
Kee Avil
Spine
CST178 180gLP + 6 Art Prints • CD • DL
€22,95
€17,22
€22,95
€17,22
€10,95
€8,22
€5,95
€4,47
€5,95
€4,47
AMERICAN VINYL SHIPPING
$8 USD - any quantity
CANADIAN VINYL SHIPPING
$16 CAD - any quantity
INTERNATIONAL VINYL SHIPPING
$30 CAD ($22 USD / €20 / £18 / JPY3000) +$7.00 CAD per additional LP
*Some exceptions for deluxe editions
AMERICAN VINYL SHIPPING
$8 USD - any quantity
CANADIAN VINYL SHIPPING
$16 CAD - any quantity
INTERNATIONAL VINYL SHIPPING
$30 CAD ($22 USD / €20 / £18 / JPY3000) +$7.00 CAD per additional LP
*Some exceptions for deluxe editions
€22,95
€17,22
€22,95
€17,22
€10,95
€8,22
€5,95
€4,47
€5,95
€4,47
AMERICAN VINYL SHIPPING
$8 USD - any quantity
CANADIAN VINYL SHIPPING
$16 CAD - any quantity
INTERNATIONAL VINYL SHIPPING
$30 CAD ($22 USD / €20 / £18 / JPY3000) +$7.00 CAD per additional LP
*Some exceptions for deluxe editions
AMERICAN VINYL SHIPPING
$8 USD - any quantity
CANADIAN VINYL SHIPPING
$16 CAD - any quantity
INTERNATIONAL VINYL SHIPPING
$30 CAD ($22 USD / €20 / £18 / JPY3000) +$7.00 CAD per additional LP
*Some exceptions for deluxe editions
Release Date: 03 May 2024
Duration: 39:41
Kee Avil’s music is both adventurous and intimate, intellectually challenging and emotionally resonant. The Montréal guitarist and producer’s 2022 debut LP Crease garnered plaudits from outlets like The Wire, The Quietus, Mojo and Foxy Digitalis, picking up a Canadian Juno Award nomination and Bandcamp Album Of The Day and Albums Of The Year along the way. Its intricate construction, unnerving atmospheres, and knife-edge take on avant-pop prompted comparisons to early PJ Harvey, This Heat, and Gazelle Twin. A remix EP with work by claire rousay, Ami Dang, Cecile Believe, and Pelada brought collaborative perspectives to four Crease tracks, offering new pathways within those songs.
On Spine, her sophomore album, Kee Avil strips back her heavily textured compositions, opening up a much rawer sound. She calls it folk—and while traditionalists might scoff, this is urgent music that reflects the precarity of modern life, as well as the jarring mixture of electronic and real-world interactions that have become the fabric of our day-to-day experiences.
There’s a hypnotic post-punk somnambulance to it all, using the repetition and fracturing of melodic phrases interwoven with delicate electronics to create curious and persistent hooks. While not a concept album, themes of time’s passage, remembrance, and decay crop up across multiple tracks. Each track intentionally only has four elements—guitar, electronics, and two other instruments, with Kee’s voice and guitar pushed to the front. Within this minimalist framework, the juxtaposition of beauty and discomfort that is key to the Kee Avil sound stands out in skin-prickling relief. “We’re shaped by many versions of ourselves,” says Avil. “I was looking back at these versions of myself and what could have been, what didn’t end up being and what did end up being, and going back like that through time. Seeing the future, the past.”
Spine was written in Kee Avil’s home studio after a lapse in writing while touring Crease and working on other projects. She is a well-known and respected member of the Montréal experimental scene, and formerly ran Concrete Sound Studio with Zach Scholes, who continues to work with her as a producer on Spine. Compared to the three years that went into making her debut, Spine emerged in a matter of months—a process that may also be a factor in its intensity and sharpness: “This record was much harder, like it was really discovering everything from scratch.” In her desire to not simply replicate or extend the sound of Crease, she felt she had to rip up the rule book, write in a different way, and pare back songs against her usual instincts.
Sometimes, when we work against our ingrained habits, we get to the core of who we really are. Spine is an exercise in that process. Without over-intellectualizing or being didactic, it hits immediately and emotionally, especially if you are a person who has spent much time in the process of self-examination. Kee’s voice hisses, whispers, and chants; her guitar bends and rings; electronics skitter and crackle; violin creaks like a door in the wind. There is something so evocative about the atmospheres she creates that it’s easy to overlay one’s own feelings onto her work, but to do that wholly would be to overlook one of the most important things about Spine: Kee Avil’s clear and thoughtful vision. This isn’t just the next step forward in her artistic trajectory; it’s a stunner of a record that stands on its own, a bracing and thrilling listen that has much to reveal about the contradictions inherent in being human.
jj skolnik, February 2024